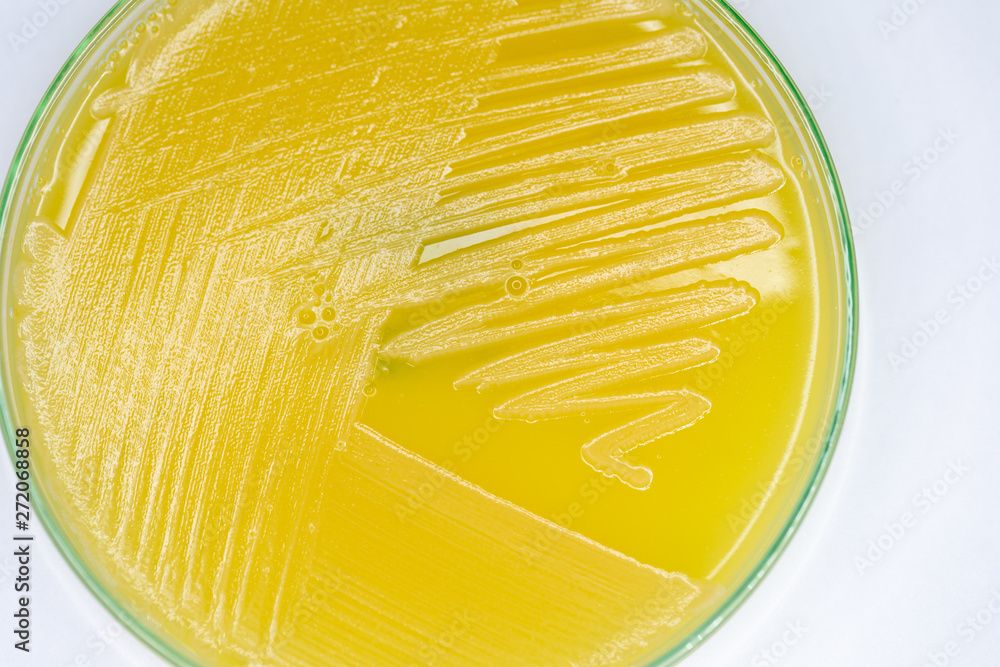
Study Colony characteristic of Actinomyces, Bacteria, yeast and Mold on

Actinomyces mediterranea es una especie de bacteria descubierta mediante Culturomics (un enfoque complementario a la metagenómica para el estudio del microbioma humano)[1] y posterior secuenciación del genoma.[2]
Fue descrita basándose en la cepa Marseille-P3257, aislada en mayo de 2016 de una muestra de lavado de duodeno de una mujer de 76 años que se sometió a una endoscopia superior para evaluar una esofagitis, la cual presenta una similitud de secuencia de 93,9 % con la cepa ATCC 51367T de A. hyovaginalis.[2] Recibe su nombre específico en referencia al mar Mediterráneo.[2]
A continuación se muestra el cladograma de la posición filogenética de A. mediterranea con otros miembros de su género de acuerdo con Mailhe, Morgane et al. (2017):[2]
Referencias
Enlaces externos
- Wikispecies tiene un artículo sobre Actinomyces mediterranea.